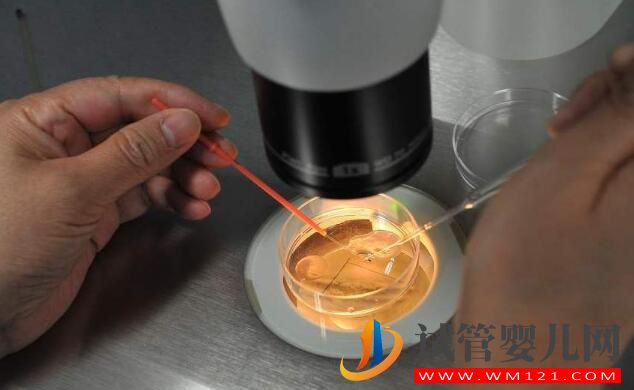
做試管嬰兒前后注意事項有哪些 準(zhǔn)備工作要怎么做(圖2)

做試管嬰兒前后注意事項有哪些 準(zhǔn)備工作要怎么做

試管嬰兒前注意事項
1、需要選擇恰當(dāng)?shù)臅r間
試管嬰兒移植的時間是有要求的,一般在做試管嬰兒的過程中,醫(yī)生會明確告知孕婦去做的時間,一定要注意遵循醫(yī)囑時間去,不要隨意的提前或者延遲。
2、在移植之前不要發(fā)生性生活
做試管嬰兒之前在半個月內(nèi)較好不要有性生活,否則有可能會對移植的成功率造成一定的影響。
3、要特別注意衛(wèi)生
試管嬰兒移植之前要注意自身衛(wèi)生狀況,如果有存在陰道炎癥等疾病,必須要先好,否則也會影響到移植的成功率。
試管嬰兒的步驟和注意事項是什么?
1、首先經(jīng)過醫(yī)生的,確定您符合做試管嬰兒的適應(yīng)癥并且沒有禁忌癥,并且您的證件齊備,則先行術(shù)前檢查,術(shù)前檢查正常后,醫(yī)生會在排卵后一周后(約在月經(jīng)第18-22天)給您使用第一次藥物。如有特殊,請遵醫(yī)囑,醫(yī)生會根據(jù)病人的情況確定您開始用超排卵藥物的時間。
2、一般于用藥后5—7天回院復(fù)查,做B超檢查、抽血,請聽從醫(yī)囑按時復(fù)診。
3、之后按醫(yī)囑,每2-4天回院監(jiān)測卵泡的發(fā)育情況,當(dāng)卵泡足夠大時,醫(yī)生會告知您注射HCG(夜針)的時間,注射夜針后36-38小時后取卵。
4、如果用藥后月經(jīng)推遲10天,請回醫(yī)院檢查。
5、由于使用促超排卵藥物,卵巢會增大,在此期間勿做劇烈運動,以免卵巢發(fā)生扭轉(zhuǎn)。
6、女方月經(jīng)第9-11天,男方需排精1次;男方取精困難者,應(yīng)提前告訴醫(yī)生、護士,以便采取相應(yīng)措施。
7、取卵之后按醫(yī)囑回中心移植胚胎,一般于取卵后第三天(取卵當(dāng)天為第零天)或第五天移植胚胎。
以上情況只是一般流程,具體的情況需根據(jù)專家的方案以及專家的安排來進行,如有任何意外或者突發(fā)情況,請及時咨詢專家尋求幫助;

試管嬰兒準(zhǔn)備工作要怎么做
1、處理現(xiàn)有的健康問題
在懷孕前解決任何復(fù)雜的健康問題,如超重,可以通過吃營養(yǎng)食品和定期鍛煉來減掉多余的體重;如慢性疾病,高血壓或甲狀腺疾病,可以通過藥物。任何健康“隱患”的存在,都會降低你自然受孕的能力。
2、遵循健康的制度
戒煙酒,常運動,好睡眠,健康吃。可以在飲食中加入新鮮蔬菜,全谷物和富含葉酸的食物,如深色多葉蔬菜,豆類和柑橘類水果。增加蛋白質(zhì)攝入量可添加雞蛋,乳制品,魚類和瘦肉。
3、保持健康的體重
“健康吃”不意味著你可以“胡吃海喝”。肥胖是導(dǎo)致不孕癥和更高BMI的主要因素之一。正常排卵率的顯著變化通常由于較高的BMI而發(fā)生。
避免劇烈節(jié)食或饑餓,因為高營養(yǎng)缺乏會極大地阻礙內(nèi)分泌激素的分泌。練習(xí)健康的運動,減掉多余的體重;避免攝入激素補充劑以減輕體重。這些補充劑嚴(yán)重影響促卵泡激素的分泌,從而降低了生育率;定期進行提高生育能力的瑜伽姿勢,促進有效的血液流入女性生殖器官。





